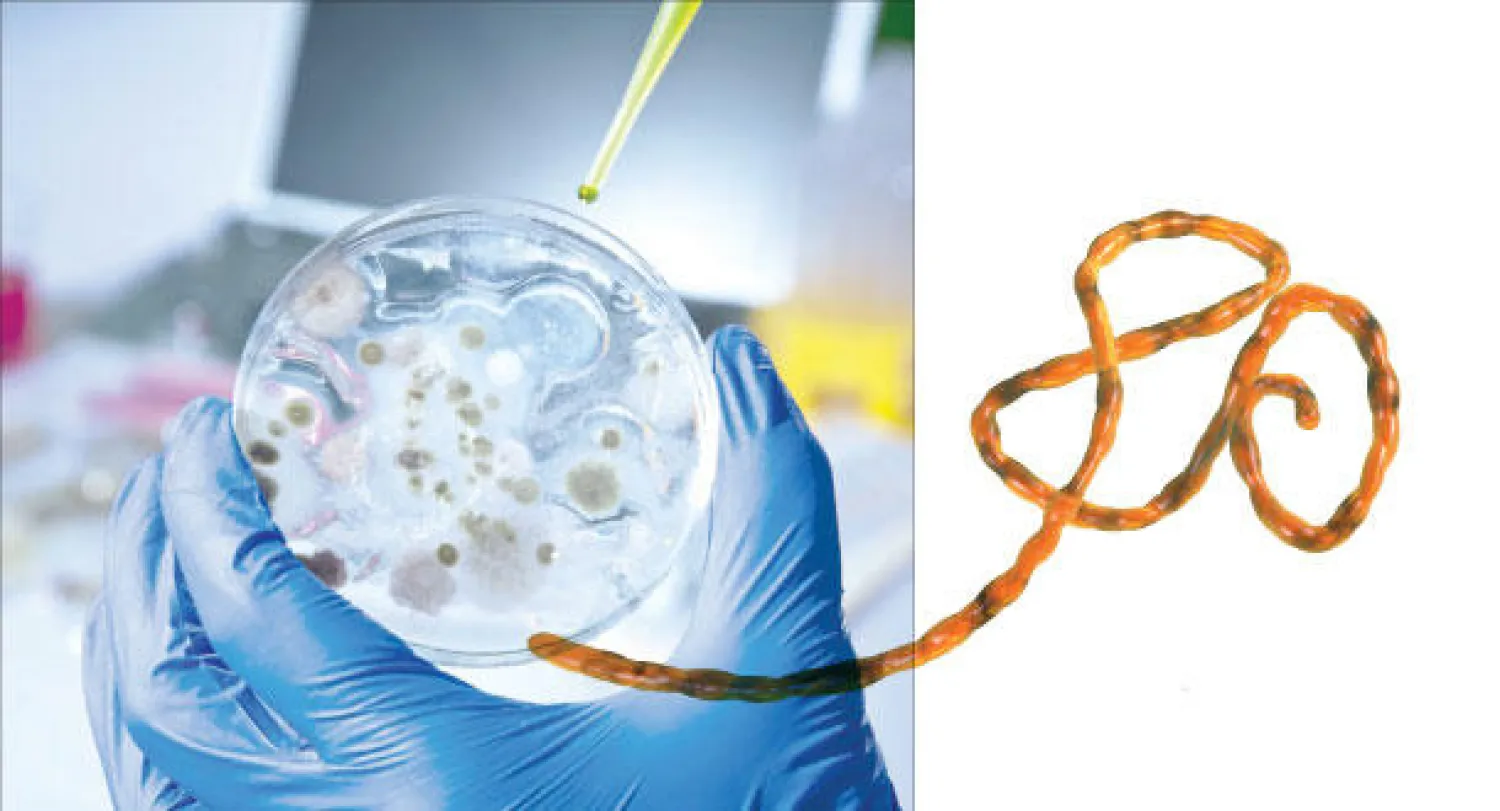
عدوى «إيبولا».. هل تنتقل عبر الرذاذ أو الهواء؟

عند الحديث عن انتقال الإصابات بالأمراض الوبائية المُعدية من المناطق الموبوءة إلى مناطق جديدة، يجدر استحضار وذكر المعلومات الأساسية لما هو معروف في الأوساط الطبية حول وسائل وكيفية انتقال العدوى. وفي شأن فيروسات إيبولا Ebola Viruses وجائحتها الوبائية الحالية، أعاد مركز السيطرة على الأمراض واتقائها CDC بالولايات المتحدة في 17 أكتوبر (تشرين الأول) الحالي تحديث نشرته الخاصة بـ«مراجعة انتقال فيروس إيبولا من إنسان لإنسان» والتي اعتمدت على مراجعة 36 دراسة ومقالة علمية في هذا الخصوص.
* وباء عالمي
* حاليا، أمست جائحة فيروسات إيبولا حديث الساعة على المستوى العالمي في الشأن الصحي، وتتصدر أخبار اكتشاف حالات جديدة للإصابات بإيبولا عناوين الأخبار بعد أن أفلتت بعض تلك الحالات من المناطق الموبوءة حاليا في غربي أفريقيا، وتحديدا من الدول الـ3 الأكثر تضررا وهي سيراليون وغينيا وليبريا. وانتقلت بعض الحالات إلى دول أخرى داخل النطاق الإقليمي في غرب أفريقيا مثل نيجيريا ومالي، وإلى دول داخل النطاق القاري للقارة الأفريقية مثل الكونغو، وعبرت نطاق البحر المتوسط إلى إسبانيا ونطاق المحيط الأطلسي إلى الولايات المتحدة. ولا يزال عدد الحالات التي خرجت عن نطاق تلك الدول الـ3 محدودا من الناحية العددية، ولكنه يظل حقيقة واقعة ضمن تعريف انتشار الإصابات خارج نطاق المناطق الموبوءة.
والسؤال الذي يتم طرحه على نطاق واسع: كيف يُمكن أن تنتقل العدوى من إنسان لإنسان؟. وهذا السؤال ليس موجها لمعرفة كيفية حصول ذلك حاليا في غرب أفريقيا، بل يطرحه سكان أوروبا وأميركا وآسيا، خاصة مع احتمالات انتقال المرض من مسافرين مقبلين من غرب أفريقيا، ويتطور السؤال إلى: هل من الممكن أن تُصيب العدوى أشخاصا كانوا جالسين بالقرب من مريض أو خالطوه، وهل ينتقل عبر الهواء أو عبر ملامسة أسطح المقاعد أو مقابض الأبواب التي لامسها شخص مُصاب؟ ولذا أفادت المراكز الأميركية أن وثيقة مراجعتها العلمية هي تلخيص موجز للمعلومات الطبية والعلمية المنشورة حول انتقال الفيروس من إنسان إلى إنسان، وأن عرض هذه المعلومات ضمن وثيقة المراجعة هو للاستخدام المباشر من قبل العاملين في مجال الرعاية الصحية والطبية وتُكملها الوثائق الأخرى التي قامت الوكالة بنشرها في موقعها الإلكتروني.
* أنواع فيروسات إيبولا
* مرض إيبولا الفيروسي Ebola virus disease (EVD) هو حمى فيروسية نزفية حادة Severe Viral Hemorrhagic Fever، تمتاز بأنها ذات معدلات وفاة عالية. وثمة 5 أنواع معروفة من فصيلة فيروسات إيبولا، منها 4 قادرة على التسبب بمرض إيبولا الفيروسي في البشر، ونوع واحد لا يتسبب بالمرض الفيروسي في البشر.
والأنواع القادرة على التسبب بالمرض بين البشر تشمل: أولا نوع «فيروس إيبولا - زائير» Ebola - Zaire الذي هو السبب وراء الجائحة الوبائية الحالية لمرض إيبولا الفيروسي، والتي تمثل أكبر جائحة لفيروسات إيبولا على مر التاريخ المعروف. وثانيا نوع «فيروس إيبولا - سودان» Ebola - Sudan، وثالثا نوع «فيروس إيبولا - ساحل العاج» Ebola - Ivory Coast، والرابع نوع «فيروس إيبولا - بينيبيغو» Ebola - Bundibugyo.. والنوع الخامس الذي لا يتسبب بمرض بين البشر هو نوع «فيروس إيبولا - ريستون» Ebola - Reston وتم اكتشافه حديثا في الفلبين.
وتفيد منظمة الصحة العالمية في نشراتها العلمية بأن مرض فيروس إيبولا هو مرض وخيم غالبا ما يكون قاتلا، حيث يصل معدل الوفاة إلى 90٪.
ويصيب المرض الإنسان والثدييات العليا غير البشرية مثل النسناس، والغوريلا، والشمبانزي. وظهر المرض لأول مرة عام 1976 في فاشيتين متزامنتين، إحداهما في قرية بالقرب من نهر إيبولا في جمهورية الكونغو الديمقراطية، والأخرى في منطقة نائية في السودان. وأصل المرض غير معروف إلا أن خفافيش الفاكهة Pteropodidae تعتبر المضيف المرجح لفيروس إيبولا استنادا إلى البيانات المتاحة. وفي الفاشية الوبائية الراهنة الحاصلة في غرب أفريقيا، وقعت غالبية الحالات لدى البشر نتيجة لانتقال الفيروس من إنسان إلى آخر.
* الانتقال باللمس المباشر
* وتحدث العدوى بسبب المخالطة المباشرة عبر الجلد أو الأغشية المخاطية المصابة مع الدم أو سوائل الجسم الأخرى أو الإفرازات، مثل البراز والبول واللعاب والسائل المنوي، للشخص المصاب. ويمكن أن تحدث العدوى أيضا إذا لامس الجلد أو الأغشية المخاطية المصابة للشخص السليم بيئات تلوثت بسوائل مريض الإيبولا المعدية مثل الملابس المتسخة، أغطية السرير، أو الإبر المستخدمة.
وتؤكد المراكز الأميركية أن انتقال فيروس إيبولا يُمكن أن يتم من خلال الاتصال المباشر مع دم وسوائل جسم أو جلد الشخص المصاب، سواء كان ذاك الشخص المصاب حيا أو ميتا.
إن فهم كيفية انتقال فيروس إيبولا وأدلة دعم تلك المعلومات هي بالأصل مبنية على 3 مصادر، وهي: بيانات نتائج تحاليل المختبرات، وبيانات نتائج الدراسات الوبائية، ونتائج الدراسات التطبيقية على الحيوانات في المختبرات.
وتفترض الدراسات الوبائية لحالات مرض إيبولا الفيروسي أن المرض انتقل إلى الإنسان بالاتصال المباشر مع حيوانات مُصابة بالفيروس، سواء اللمس الخارجي لها أو لمس سوائل جسمها أو دمها، وأنه بعد هذا الانتقال من الحيوان إلى الإنسان بدأ الانتقال بين إنسان مُصاب إلى إنسان آخر سليم. وخلال فترة المرحلة الحادة من الإصابة ترتفع معدلات تكاثر الفيروس في الجسم، ويرافق ذلك الارتفاع في أعداد الفيروس بالجسم ظهور أعراض ارتفاع الحرارة والقيء والإسهال والنزيف الدموي غير ذي سبب Unexplained Bleeding. ولذا تمثل هذه الفترة، والتي يُستدل عليها بالأعراض المتقدمة الذكر، مرحلة ارتفاع احتمال التسبب بعدوى الأشخاص الآخرين.
ولاحظت نتائج الدراسات الوبائية أن الأشخاص الذين اتصلوا بشكل مباشر مع المرضى بإيبولا، وتحديدا لامسوا جلدهم أو دمهم أو سوائل جسمهم، انتقلت لهم العدوى، بينما الأشخاص الذين لم يفعلوا ذلك لم تنتقل إليهم العدوى. وبشيء من التفصيل، فإن الأشخاص الذين عاشوا مع مرضى في نفس المنزل ولم يلمسوهم بشكل مباشر ولم يلمسوا سوائل جسمهم ولم يلمسوا دمهم، لم تنتقل إليهم العدوى. وهناك أدلة علمية على حصول حالات إصابة لأشخاص استخدموا أغطية فراش سبق أن استخدمها مريض مُصاب بإيبولا.
* سوائل الجسم
* وتشير نتائج تحليل بيانات المختبرات إلى أن فيروس إيبولا يُمكن بالكاد اكتشافه في دم الشخص المصاب مع بدء ارتفاع حرارة الجسم وظهور الأعراض، وأن هناك زيادة في احتمالات اكتشاف الفيروس في دم المُصاب مع مرور الأيام التالية، وأجسام المرضى المتوفين تحتوي أعدادا أكبر من الفيروسات. وهناك مؤشرات لدى بعض المرضى تدل على أن الأعراض ظهرت عليهم ولم يتم اكتشاف الفيروس في الدم إلاّ بعد 3 أيام. وبالنسبة للمرضى الذين بدأوا يتماثلون للشفاء، تنخفض تدريجيا الفيروسات في دمهم وسوائل جسمهم الأخرى.
وسوائل الجسم المقصودة تشمل: اللعاب ورطوبة سطح الجلد وحليب الثدي ودموع العين والبول والبراز والسائل المنوي والسائل المهبلي وسائل القيء والبلغم والعرق.
ومن مجمل نتائج الدراسات المختبرية تمت ملاحظة مدة بقاء الفيروس في السوائل المختلفة للجسم خلال مرحلة النقاهة، أي بعد زوال شدة المرض، وفق النتائج التالية: 101 يوم في السائل المنوي، 33 يوما في سائل المهبل، 29 يوما في مسحة المستقيم، 23 يوما في سائل البول، 21 يوما في الدم، 15 يوما في حليب الثدي، 8 أيام في سائل اللعاب، 6 أيام في رطوبة سطح جلد كف اليد.
* الإصابة بالعدوى
* ولذا تلخص منظمة الصحة العالمية هذه النقاط بقولها الفقرة التالية: «ويعتبر الأشخاص مصابين بالعدوى طالما احتوت دماؤهم وإفرازاتهم على الفيروس. ولهذا السبب يخضع المصابون بالعدوى لرصد وثيق من جانب المهنيين الطبيين وتُجرى لهم اختبارات مختبرية لضمان أن الفيروس لم يعد يسري في أنظمتهم قبل عودتهم إلى منازلهم. وحينما يقرر المهنيون الطبيون أن بمقدور المرضى العودة إلى المنزل فهذا يعني أنهم قد تخلصوا من العدوى ولم يعد بمقدورهم نقلها إلى أي شخص آخر في مجتمعاتهم المحلية. ويمكن للرجال الذين يتعافون من المرض نقل الفيروس إلى شريكاتهم عبر السائل المنوي خلال فترة تصل إلى 7 أسابيع بعد التعافي. ولهذا فإن من المهم أن يمتنع الرجال عن إقامة علاقات جنسية لمدة 7 أسابيع على الأقل بعد التعافي أو استخدام العوازل الذكرية في حال إقامة علاقات جنسية خلال فترة الأسابيع الـ7 بعد التعافي. وقد حدثت حالات انتقال إضافية في المجتمعات أثناء الجنازات وطقوس الدفن. وقد لعبت مراسم الدفن التي يكون فيها المشيعون على اتصال مباشر مع جثمان المتوفى دورا في انتقال الإيبولا. فالأشخاص الذين لقوا حتفهم من جراء فيروس الإيبولا يجب التعامل معهم باستخدام ملابس وقفازات الوقاية القوية، وأن يتم دفنهم على الفور. وتوصي المنظمة بضرورة تولي مهنيين مدربين على التعامل مع الحالات ومجهزين لدفن الجثمان بشكل صحيح، التعامل مع المتوفى ودفنه. وعليه تكون الفئات الأكثر تعرضا للخطر خلال اندلاع الفاشيات هي: العاملون الصحيون، وأفراد الأسر أو ذوو الاحتكاك الوثيق مع المصابين بالعدوى، والمشيعون الذين يحتكون مباشرة بجثامين المتوفين كجزء من الطقوس الجنائزية»، انتهى الاقتباس من كلام منظمة الصحة العالمية.
* الانتقال عبر الرذاذ
* علينا بداية أن نفهم دور الهواء في انتقال العدوى لأي ميكروب، كالفيروس أو البكتيريا أو الفطريات.
هناك نوعان من وسائل الانتقال الهوائية، نوع أول هو «عدوى عبر الهواء» Airborne Transmission، ونوع ثان هو «عدوى عبر الرذاذ» Droplet Transmission. العدوى التي تنتقل عبر الرذاذ يكون فيها وجود الميكروب داخل كتلة مائية بحجم أكبر من 10 ميكرومترات micrometer (الميكرومتر أو الميكرون: واحد من المليون من المتر)، وهذه الكتلة تطير في الهواء بعدما يعطس أو يسعل الشخص أو حينما يتكلم. وإذا علقت أو وصلت هذه الكتلة المائية المُحمّلة بالميكروب إلى سطح نسيج رطب في جسم الإنسان فإنها تعطي فرصة للميكروب أن يلتصق بجسم الشخص السليم ومن ثم يتكاثر عليه الميكروب ويتغلغل في جسمه وتحصل العدوى. أي إن تلك القطرة الصغيرة جدا من الرذاذ المائي، التي لا تُرى بالعين المجردة، تعمل كمركبة نقل لنقل الميكروب من شخص مريض إلى شخص سليم.
وهذه القطرات من الرذاذ المائي لا تقدر في الغالب أن تنتقل أكثر من مترين، وهي إما أن تلتصق بجسم شخص سليم أو تسقط لتلصق بأشياء صلبة كسطح الطاولة أو مقبض الباب أو سماعة الهاتف أو غيرها. وحينما تسقط على أشياء صلبة جامدة، يعتمد بقاؤها حية على قدراتها على الحياة في تلك الظروف البيئية، أي الحرارة ودرجة الرطوبة وتوفر الغذاء، وبالتالي تعتمد على هذه الأمور قدراتها على عدوى إنسان آخر حينما يلامس ذلك السطح.
وهناك احتمال آخر لهذه الكتلة من الرذاذ المائي، وهو أن يتبخر جزء كبير من الماء فيها ويبقى الميكروب ضمن كتلة مائية ضئيلة جدا، وهنا يتكون لدينا كتلة قطرها لا يتجاوز 5 ميكرونات. وهناك ميكروبات قادرة على العيش في هذه الظروف القاسية جدا، وبالتالي قادرة على عدوى شخص سليم على بُعد عشرات الأمتار أو أكثر.
ومن أمثلة الميكروبات التي تنتقل بنوع «عدوى عبر الهواء» الجدري المائي والسل والحصبة والحصبة الألمانية وغيرها. ولذا يُمكن أن يُصاب طفل بالجديري المائي أو الحصبة بمجرد وجود طفل آخر في المدرسة بنفس المرض أو وجود الطفل في متجر كبير (سوبرماركت) ووجود طفل آخر مُصاب بالحصبة الألمانية في نفس المكان، وهما لم يلتقيا وجها لوجه. ومن أمثلة الميكروبات التي تنتقل بنوع «عدوى عبر الرذاذ» ميكروبات الطاعون والإنفلونزا ونزلات البرد.
* الانتقال عبر الهواء
* وبالنسبة لفيروس إيبولا، لا شك أنه قادر على الانتقال بـ«عدوى عبر الرذاذ»، ولكن مراجعة مركز السيطرة على الأمراض واتقائها بالولايات المتحدة تشير إلى أن هناك افتراضا بأن فيروس إيبولا قادر على الانتقال بـ«عدوى عبر الهواء»، وهو ثابت في التجارب على الحيوانات، ولكنها تُعقب بالقول إن ذلك لم يثبت لدى البشر. واعتمدت المراجعة على نفي إثبات وتوثيق حصول حالات عدوى لمرضى بإيبولا دونما وجود اتصال مباشر مع مرضى، وهي وإن كانت حجة قوية علميا إلا أنه من الصعب الاعتماد عليها بالمطلق في الجزم بعدم احتمال حصول ذلك والأهم خلط الناس فيما بين تبعات فهم نوعي العدوى التي يُمكن أن تنتقل عبر الهواء وعبر الرذاذ، وذلك على وجه الخصوص لـ3 أسباب، السبب الأول منطقي وبسيط ومفاده أن عدم ثبوت إصابة بشرية بالعدوى عن هذا الطريق لا يعني تأكيد نفي احتمال تسبب هذا الطريق بالعدوى، خاصة أن من الثابت علميا وجود الفيروس في سوائل الجهاز التنفسي للمريض. والسبب الثاني أن تجارب العدوى في المختبرات أثبتت انتقال العدوى عبر الهواء فيما بين حيوانات المختبرات كالقرود، أي إنه عندما حُقنت تلك الفيروسات في جسم قرود موجودة في قفص، ووضعت بالقرب منها، وبمعزل عن التلامس المباشر فيما بينها، قرود سليمة في أقفاص أخرى، فإن المرض انتقل إلى القرود السليمة. والسبب الثالث أنه في المرحلة الحالية من تفشي وباء إيبولا بشكل لم يسبق له مثيل، لا نعلم بدقة كيفية سلوك هذه النوعيات من الفيروسات التي ثبت أنه حصل لديها بعض التغيرات في بنيتها وربما سلوكياتها وقدراتها بالمقارنة مع أصولها من الكونغو لفيروسات زائير التي انتشرت قبل عقد من الزمان.
وصحيح أن المراجعة العلمية أشارت إلى أن حالات عدوى إيبولا التي أصابت العاملين في مجال الخدمات الصحية كانت بسبب عدم اتباع الإرشادات الطبية في العزل والوقاية من الملامسة المباشرة، وهو ما تؤكده أيضا منظمة الصحة العالمية بخصوص تلك الحالات، إلا أن الأمر لا يزال يحتاج إلى توثيق ومزيد من البحث عبر مراجعة الحالات وكيفية إصابتها بالعدوى.
* استشارية في طب الباطنية